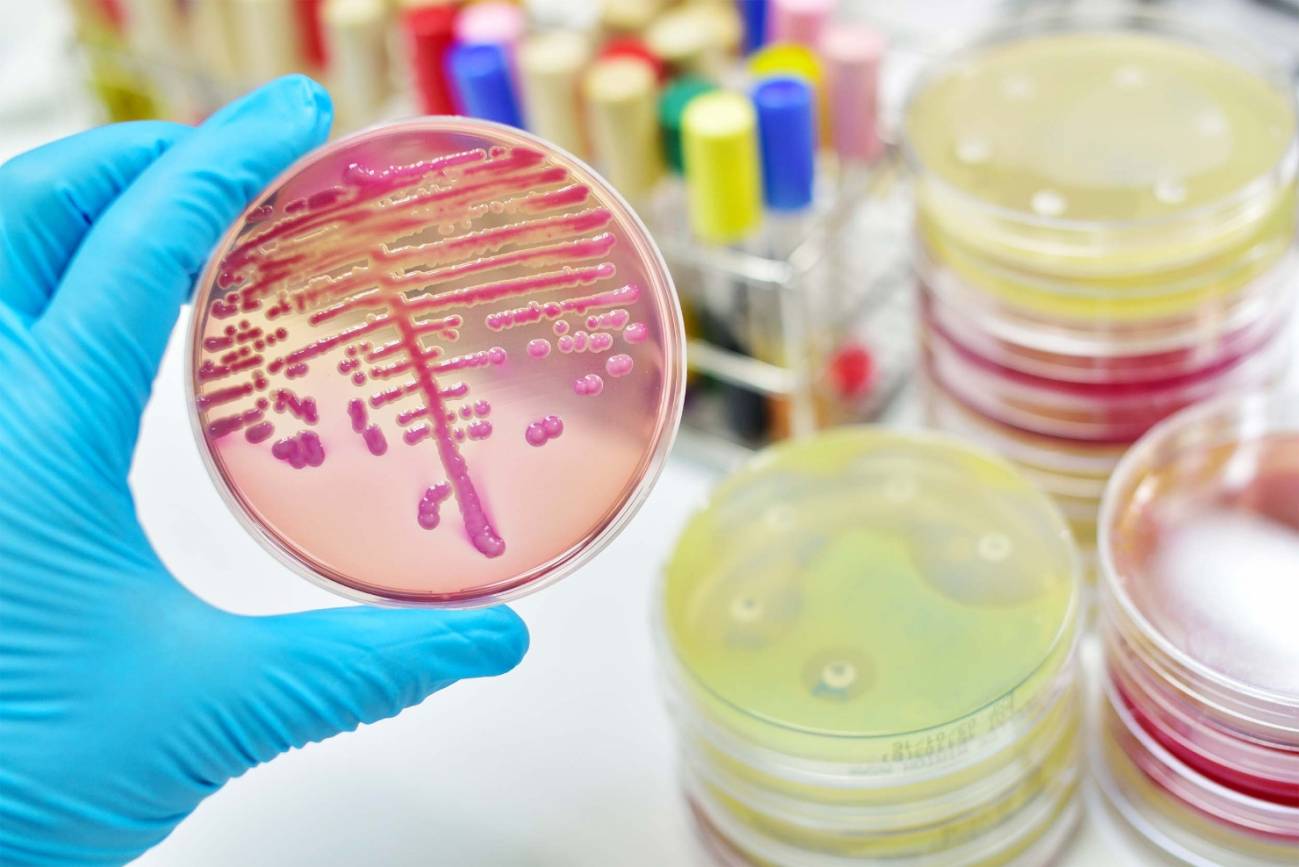
Bacterias

Reacción: crean un nuevo antimicrobiano sintético efectivo frente a bacterias multirresistentes
La cresomicina, una nueva molécula sintética, muestra una eficacia robusta contra múltiples formas de resistencia antimicrobiana (AMR) evolutivamente divergentes, según un estudio publicado hoy en Science. Mediante el análisis estructural de cómo los antibióticos se unen a ribosomas de diversas especies bacterianas, los investigadores desarrollaron una nueva molécula antibiótica que adopta la conformación exacta necesaria para la unión ribosomal.
0